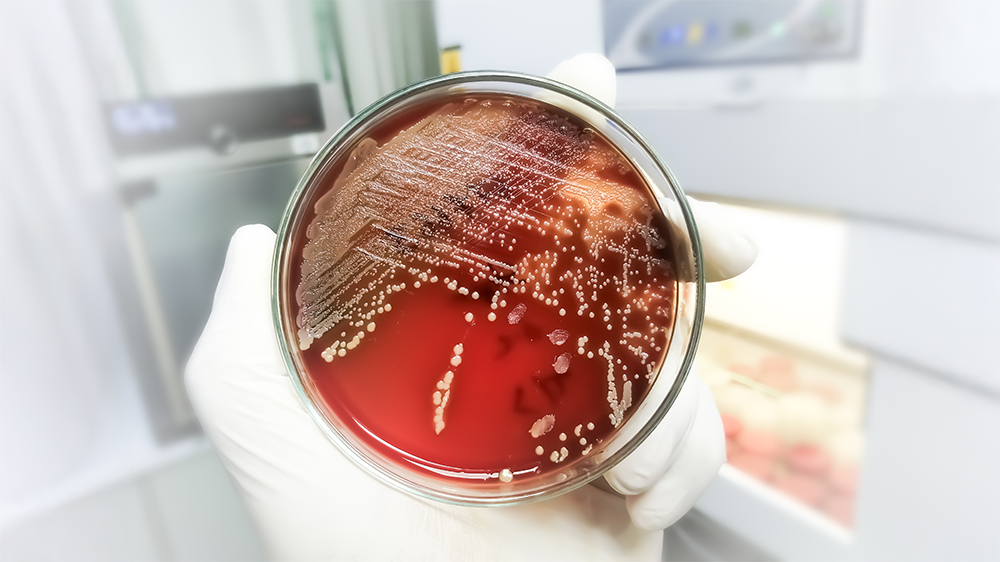
Winning The Fight Against Superbugs

Imagine a perfectly healthy person visiting a gym, grabbing a dumbbell, wiping the sweat off their brow … and unknowingly picking up a dangerous, antibiotic-resistant bacteria. Fast forward a day or two later and that person is in a doctor’s office being treated for a painful, and possibly quite serious skin infection. Welcome to the world of MRSA.
MRSA, an acronym for Methicillin-Resistant Staphylococcus Aureus, is a formidable bacterial opponent that thrives on high touch surfaces and laughs in the face of many traditional antibiotics and other antimicrobials. Fortunately, there’s one strategy that consistently works to keep MRSA in check: Disinfection. And when it comes to choosing the right disinfectant for the job, PermaSafe CLEAN stands tall as a powerful, EPA-registered solution that combines cutting-edge science and safety with everyday usability. In fact, it’s also one of the only antimicrobial products available in the US that meets the Centers for Disease Control and Prevention’s (CDC’s) standards of An Ideal Disinfectant.
Let’s dig into why disinfection is essential in the battle against MRSA and how PermaSafe CLEAN is built to win it.
What is MRSA and Why Should You Care?
MRSA is a type of Staphylococcus Aureus that has developed resistance to commonly used antibiotics and other antimicrobials, including many disinfectants. And while it was once primarily found in hospitals, that hasn't been the case for some time now. Today, MRSA infections are showing up in schools, gyms, locker rooms, and even homes and offices. MRSA infections range from mild skin irritations to lifethreatening lung, heart, and bloodstream infections, with one of its most alarming aspects being how easily it spreads through simple contact with contaminated surfaces.
MRSA can be contracted from wrestling mats, desk tops, tabletops, counter tops, door handles, computer mice, your child’s tablet, and thousands of other surfaces. Even more frightening is the fact that MRSA can survive on these surfaces for days, waiting to hitch a ride to its next host. That’s why cleaning alone isn't enough - you need a disinfectant that can actually KILL the bacteria.
Disinfection: Your First Line of Defense.
Cleaning surfaces is always good, as it gets rid of dirt and grime that can be unsightly, while also harboring germs. However, when it comes to protecting you and yours against infectious disease, disinfection is king. Disinfecting actually kills the disease causing germs that lurk on surfaces, a critical distinction when you're dealing with tough pathogens like MRSA. But it’s equally critical to note that not all disinfectants are created equal. To be effective against MRSA, a product must be specifically evaluated and EPA-registered for killing MRSA. This is where PermaSafe CLEAN shines.
Meet PermaSafe CLEAN: The Super- Hero of Surface-Hygiene.
PermaSafe CLEAN isn't your average disinfectant cleaner. It’s a 12-in-1, All-Purpose, All-Surface Cleaner; No-Rinse, No-Wipe, Hard, Soft and Food Contact Surface Sanitizer; Advanced Level, Broad-Spectrum, Hospital Disinfectant; Heavy Duty Surface & Air Odor Eliminator; Mold, Mildew and Fungi Killer; Allergen Remover; and HVAC System Microbial Growth and Odor Remover … that does it all and more without the use of any harsh or hazardous chemicals.
Whether you're tackling dirty gym equipment or sanitizing kitchen counters, PermaSafe CLEAN gets the job done - with confidence.
Kills 99.999% of Harmful Bacteria in as Little as 60 Seconds.
When used as directed, PermaSafe CLEAN effectively disinfects hard, nonporous surfaces, eliminating up to 99.999% of a broad spectrum of pathogens, including Staphylococcus Aureus (the bacteria MRSA is derived from) as well as H1N1; Norovirus; HIV; RSV; Legionella; Pseudomonas Aeruginosa; Mycobacterium Tuberculosis; Hepatitis A, B, and C; Ebola Virus; SARS-CoV-2, and many more (View Complete List). This means that high-risk surfaces like tabletops, countertops, bathroom sinks, doorknobs, gym equipment, and many others can be turned from bacteria-filled to bacteria-free in as few as 60 seconds.
Why People Love CLEAN: It’s a Germ’s Worst Nightmare, and a Homeowner’s Dream.
PermaSafe realizes that no one wants to expose themselves or others to harsh or hazardous chemicals or chemical fumes, nor do they want to spend any more time cleaning or killing germs than is necessary. PermaSafe CLEAN was designed to deliver fast, effective, high level, all surface hygiene, and it does! Here are just a few of the unique features that make it stand out:
-
Potent Yet Gentle: Despite its broad-spectrum, pathogen-pulverizing capabilities, colorless, odorless, water-based CLEAN is mild enough to use every day, in any environment, including in nurseries and food service areas. In fact, it’s so mild, you can wash your hands in it.
- No Rinse Needed (Even on Food-Contact Surfaces): That's right, when used as directed, CLEAN eliminate 99.999% of bacteria on food contact surfaces with no need to wipe or rinse treated articles after it applied, even on babies’ pacifiers. This means faster cleaning and sanitizing, with fewer steps, for restaurants, daycare centers, and homes alike.
- Multi-Surface Magic: Unlike most antibacterial products, which are only effective on hard, nonporous surfaces, CLEAN eliminates harmful bacteria on virtually every type of surface, be it hard, soft, porous, nonporous, food contact or medical. Use it on countertops, yoga mats, carpet, tile, stainless steel, glass, tableware, bedding, fabrics, and even inside your HVAC air ducts. From living rooms to locker rooms, and most everything in between, if you’re looking for surface hygiene, look no further than CLEAN.
- True One-Step Hygiene: CLEAN is EPA registered and certified to Clean, Disinfect, and Deodorize, all in one time-saving, no rinse, no wipe, “spray and walk away” step, making it the fastest, easiest to use product of its kind.
- Laboratory-Tested, EPA, NSF and FDA Certified: PermaSafe CLEAN meets the highest industry performance and safety standards for cleaning, sanitizing, disinfection and more. These claims aren't just about marketing, but institutionally verified efficacy.
Equally Effective Against MRSA’s Favorite Mates: Mold & Mildew.
MRSA isn't the only threat lurking in dark, damp places. Mold and mildew are often found in the same environments, feeding off moisture and contributing to respiratory problems. Thankfully, PermaSafe CLEAN is also an EPA registered and certified mildewstat and fungicide that offers powerful protection wherever mold might thrive, such as in bathrooms, basements, laundry rooms, damp carpeting, and HVAC air ducts. When used as directed, CLEAN:
-
Kills mold and mildew, and prevents their regrowth for up to 4 weeks.
- Eliminates & controls Trichophyton Interdigitale, the fungus that causes athlete’s foot.
For Homes, Offices, Hospitals, Schools, Gyms, and Beyond.
PermaSafe CLEAN’s 12-1, all-purpose, all-surface cleaning, sanitizing, disinfecting, deodorizing, and mold, mildew, fungi and allergen eliminating versatility make it a must have for every person, place, surface and space.
-
At Home: Safe to use and effective on virtually every surface and material in every room and space in your home. Use it to clean and sanitize everything from baby’s bottles, toys, changing table and crib, to pet areas, and every other area and thing in between.
- At the Office: If you can touch it, CLEAN can clean and sanitize it. From computer mice, touchscreens, keyboards, and cellphones to bathroom fixtures, light switches, doorknobs, flooring, and carpet stains, CLEAN does them all!
- In Healthcare Facilities: Effective on high touch surfaces such as exam tables, handrails, waiting room furniture, blood pressure monitors, and hundreds more.
- In Schools: Use “spray and walk away” CLEAN to clean, disinfect, and deodorize lockers, tables, desks, chairs, pencils, pens, computers and every other surface of concern.
- In Gyms: CLEAN disinfects and deodorizes mats, benches, weight plates and machines with ease. Say goodbye to sweaty smelling spaces and hello to safe, sanitized, and fresh-smelling surfaces.
-
In HVAC Systems and Air Ducts: CLEAN is even EPA registered and approved for use in HVAC systems and air ducts, helping to keep them microbe free, smelling fresh, and working properly.
A Cleaner, Safer Tomorrow Starts With CLEAN, and Can Begin Today.
In a world where antimicrobial-resistant bacteria like MRSA are no longer confined to hospitals, the responsibility of protecting our homes, businesses, and communities falls on all of us. Fortunately, with proven, no nonsense, uniquely safe and effective products like PermaSafe CLEAN, that responsibility becomes a whole lot easier to manage.
Visit www.PermaSafe.com to learn more about PermaSafe CLEAN and how it can transform the way you clean, sanitize, and protect every surface and space in your place. Whether you’re a parent, a facility manager, or a business owner, when it comes to germs, PermaSafe CLEAN gives you the confidence to say: “There’s nothing to fear when visiting here!”

Leave a comment
All comments are moderated before being published.
This site is protected by hCaptcha and the hCaptcha Privacy Policy and Terms of Service apply.